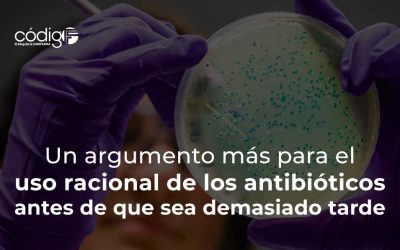
Un argumento más para el uso racional de los antibióticos antes de que sea demasiado tarde

Autotrasplante de útero: la opción para preservar la capacidad de gestación en mujeres que serán tratadas por un cáncer en la zona pélvica
“Se trata de cambiar la anatomía de un órgano de la pelvis, situándolo en otra ubicación. Lo dejamos con la vascularización necesaria para garantizar su viabilidad y, una vez completado el tratamiento oncológico, lo devolvemos a su ubicación normal”. Dra. Gemma...
Piel humana fabricada a partir de células de pacientes quemados, sin riesgo de rechazo
“El perfil del paciente que se beneficia de esta cobertura es muy concreto: no pueden presentar infecciones activas en la superficie cutánea y suelen tener de un 60 a un 90 % de su superficie corporal quemada en los pacientes adultos, y más del 30 % si se trata de un...
El 10% de las mujeres que contrajeron COVID-19 durante el embarazo tienen secuelas posagudas de la infección
Estaba plenamente establecido que el COVID-19 durante el embarazo aumentaba las probabilidades de hospitalización o muerte, en comparación con su contagio sin embarazo, infección que incrementaba además el riesgo de parto prematuro o muerte fetal. Lo que no se sabía,...
Un argumento más para el uso racional de los antibióticos antes de que sea demasiado tarde
“El uso de antibióticos en los primeros años de vida altera la colonización microbiana y aumenta el riesgo de desarrollar alergias y asma en adultos”. ImmunityAdemás de constatar con preocupación la gravísima pérdida de efectividad de los antibióticos contra la acción...
Descubren una hormona capaz de crear nuevo tejido óseo y evitar la osteoporosis
La hormona se activa en las madres que amamantan a sus hijos, y que a pesar de ello no pierden masa ósea. Su descubrimiento puede potenciar el desarrollo de nuevos tratamientos contra esta grave condiciónUna de las preguntas que impulsaron la investigación realizada...
Descubren un circuito cerebral involucrado en el reconocimiento de caras
Hay un refrán que dice “ignoramos la digestión, hasta que algo va mal en ella”, y creo que esta sentencia puede aplicarse fácilmente a todas las demás funciones que realiza nuestro organismo, a las que generalmente no les prestamos atención ni nos maravillan, hasta...